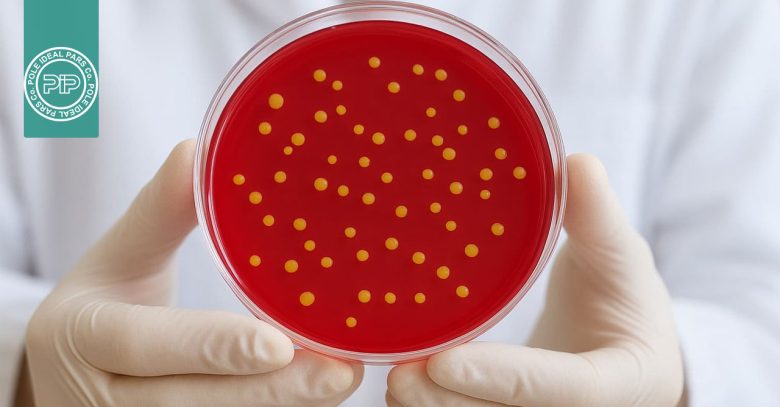
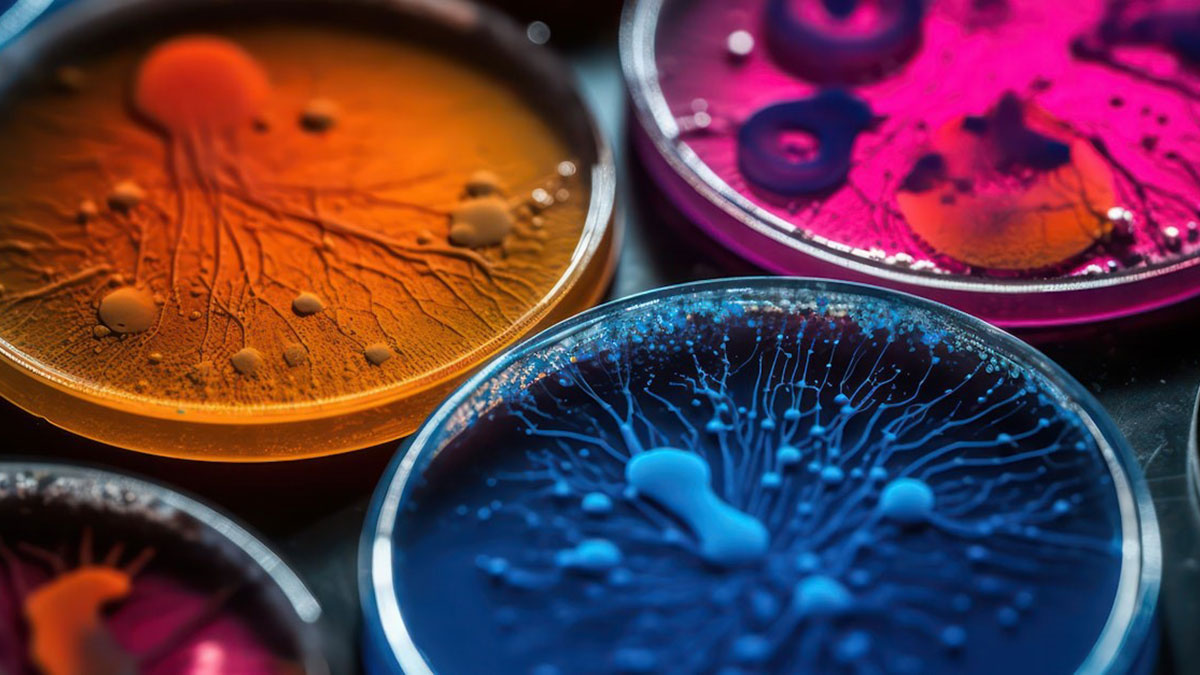
پتری دیش یک ظرف کوچک

پتری دیش چیست؟ آشنایی کامل با کاربردها، ویژگیها و اجزای این ابزار مهم آزمایشگاهی
پتری دیش یکی از پایهایترین و در عین حال مهمترین ابزارها در آزمایشگاههای زیستشناسی و میکروبیولوژی است. این ظرف ساده نقش بزرگی در کشف میکروارگانیسمها، بررسی رشد سلولها و انجام تحقیقات علمی دارد. از آزمایشهای دانشجویی گرفته تا پژوهشهای پیشرفته، پتری دیش تقریباً همیشه بخشی از فرایندهای آزمایشگاهی محسوب میشود.
در این مقاله قرار است بهصورت کامل با انواع پتری دیش آشنا شوید، اجزای آن را بشناسید و کاربردهای مهمش را یاد بگیرید. همچنین چند مثال واقعی بررسی میکنیم تا ببینید این ابزار چگونه در دنیای علم استفاده میشود. اگر میخواهید درک عمیقتر و کاربردیتری از پتری دیش داشته باشید، این راهنما دقیقاً همان چیزی است که به آن نیاز دارید.
پتری دیش چیست؟ آشنایی با یکی از مهمترین ابزارهای آزمایشگاهی
پتری دیش یک ظرف کوچک، کمعمق و شفاف بههمراه یک درپوش است که بیشتر در آزمایشهای زیستی استفاده میشود. این ابزار ساده اما بسیار کاربردی، محیطی کنترلشده ایجاد میکند تا بتوان سلولها را بهراحتی کشت داد و رشد آنها را بررسی کرد. شفاف بودن پتری دیش به پژوهشگران اجازه میدهد بدون باز کردن درپوش، تغییرات و روند رشد نمونهها را مشاهده کنند و خطر آلودگی را کاهش دهند.
برای مثال، در آزمایشهای میکروبیولوژی، پتری دیش بهعنوان یک ظرف مناسب برای پرورش میکروبها به کار میرود. داخل این ظرف معمولاً مادهای به نام «محیط کشت» قرار میدهند که مواد مغذی لازم را برای رشد میکروارگانیسمها فراهم میکند. این شرایط باعث میشود دانشمندان بتوانند رفتار، تکثیر و ویژگیهای میکروبها را با دقت بیشتری مطالعه کنند.
نام پتری دیش از مخترع آن، یولیوس ریچارد پتری (Julius Richard Petri)، باکتریشناس آلمانی گرفته شده است. به همین دلیل، این ظرف در برخی منابع با نامهای دیگری مثل پلیت پتری یا پلیت کشت نیز شناخته میشود، اما همه این اصطلاحات به همین ابزار پرکاربرد آزمایشگاهی اشاره دارند
تاریخچه پتری دیش؛ اختراعی که دنیای میکروبشناسی را متحول کرد

داستان پتری دیش به قرن نوزدهم بازمیگردد؛ زمانی که «یولیوس ریچارد پتری»، باکتریشناس آلمانی، هنگام کار در آزمایشگاه «رابرت کخ» برای نخستین بار این ابزار را ابداع کرد. پتری در آن دوره بهعنوان دستیار رابرت کخ، یکی از مشهورترین میکروبیولوژیستهای جهان، فعالیت میکرد و از نزدیک با چالشهای کشت باکتریها روبهرو بود.
در آن زمان، باکتریها معمولاً در لولههای آزمایش یا فلاسکهایی که حاوی محیط کشت جامد بودند رشد داده میشدند. اما این روش مشکلات زیادی داشت. مشاهده دقیق کلنیهای باکتریایی دشوار بود و جابهجایی یا کار کردن با نمونهها بهسادگی انجام نمیشد. همین محدودیتها باعث شد نیاز به ابزاری کاربردیتر بهشدت احساس شود.
پتری با بهبود روشهای قدیمی، ظرفی کمعمق و تخت طراحی کرد که امکان مشاهده راحتتر و دستکاری سادهتر کلنیهای باکتری را فراهم میکرد. این طراحی جدید به دانشمندان کمک کرد تا رشد میکروارگانیسمها را با دقت بیشتری بررسی کنند و آزمایشها را کنترلشدهتر انجام دهند.
سرانجام، در سال ۱۸۸۷، پتری نتایج کار خود را در مقالهای با عنوان «Eine kleine Modification des Kochschen Platten Verfahrens» (به معنی «اصلاح کوچکی در روش پلیت کخ») منتشر کرد. او در این مقاله، ساختار و کاربردهای این ظرف را توضیح داد؛ ظرفی که بعدها به افتخار او پتری دیش نام گرفت و به یکی از ضروریترین تجهیزات آزمایشگاهی در سراسر جهان تبدیل شد.
اجزای پتری دیش؛ آشنایی با ساختار این ظرف کاربردی آزمایشگاهی

پتری دیش از چند بخش ساده اما بسیار مهم تشکیل شده است که هر کدام نقش خاصی در فرایند کشت و بررسی نمونهها دارند. شناخت این اجزا به شما کمک میکند تا هنگام کار در آزمایشگاه، دقت و کنترل بیشتری داشته باشید.
مهمترین بخشهای پتری دیش شامل یک ظرف شفاف و یک درپوش یا پوشش محافظ است. شفاف بودن این ظرف باعث میشود بتوان بدون باز کردن آن، رشد میکروارگانیسمها یا سلولها را مشاهده کرد. این ویژگی خطر آلودگی را کاهش میدهد و ایمنی آزمایش را افزایش میدهد.
معمولاً برای محکمتر بسته شدن پتری دیش از نوار پارافیلم استفاده میشود. این نوار انعطافپذیر دور ظرف پیچیده میشود و از ورود آلودگیهای محیطی جلوگیری میکند. در نتیجه، شرایط داخلی ظرف برای رشد نمونهها پایدارتر باقی میماند.
بخش پایینی پتری دیش در واقع قسمت بزرگتر آن است که محیط کشت داخل آن قرار میگیرد و یک پایه ثابت برای ظرف ایجاد میکند. این قسمت اغلب سطحی صاف دارد و لبههای آن کمی برجسته طراحی شدهاند تا از سرریز شدن محیط آگار جلوگیری شود.
همچنین، اطلاعات مهمی مانند تاریخ، نام نمونه، نوع محیط کشت و هر توضیح ضروری دیگر معمولاً روی بخش پایینی پتری دیش نوشته میشود. این کار از اشتباهات احتمالی جلوگیری میکند و به سازماندهی بهتر نمونهها در آزمایشگاه کمک میکند.
جالب است بدانید که درپوش پتری دیش معمولاً کمی بزرگتر از بخش پایینی طراحی میشود. این تفاوت اندازه باعث میشود درپوش بهراحتی روی ظرف قرار بگیرد و در عین حال جریان هوای اضافی وارد آن نشود. مانند قسمت پایینی، درپوش نیز شفاف است؛ بنابراین پژوهشگران میتوانند بدون باز کردن ظرف، نمونههای داخل پتری دیش را بهسادگی مشاهده کنند. این ویژگی هم دقت بررسی را بالا میبرد و هم احتمال آلودگی را کاهش میدهد.
انواع پتری دیش؛ آشنایی با مدلهای مختلف این ابزار حیاتی

پتری دیش بر اساس ویژگیهای مختلفی دستهبندی میشود. شکل، قابلیت استفاده، جنس و حتی تعداد بخشهای داخلی، همگی در انتخاب نوع مناسب تأثیر دارند. شناخت انواع پتری دیش به شما کمک میکند بهترین گزینه را متناسب با نیاز آزمایشگاهی خود انتخاب کنید و دقت نتایج را افزایش دهید.
انواع پتری دیش بر اساس شکل
بیشتر مدلهای پتری دیش به شکل استوانهای ساخته میشوند و قطر آنها معمولاً بین ۳۰ تا ۲۰۰ میلیمتر است. این طراحی استاندارد باعث میشود فضای کافی برای رشد کلنیها فراهم شود و مشاهده آنها آسانتر باشد.
با این حال، تنها گزینه موجود همین شکل نیست. پتری دیشهای مربعی و مستطیلی نیز تولید میشوند. این مدلها برای آزمایشهایی که به چیدمان منظم نمونهها یا استفاده بهینه از فضا نیاز دارند، بسیار کاربردی هستند.
انواع پتری دیش بر اساس قابلیت استفاده
از نظر دفعات مصرف، پتری دیشها به دو گروه اصلی تقسیم میشوند:
پتری دیشهای قابل استفاده مجدد
این مدلها دوام بالایی دارند و میتوانند چندین بار تحت فرایندهای استریلیزاسیون خشک یا مرطوب قرار بگیرند بدون اینکه کیفیت خود را از دست بدهند. به همین دلیل، گزینهای مقرونبهصرفه برای بسیاری از آزمایشگاهها محسوب میشوند.
پتری دیشهای یکبارمصرف
این نوع پس از یک بار استفاده دور انداخته میشود. مزیت اصلی آن کاهش خطر آلودگی متقاطع است؛ موضوعی که در آزمایشهای حساس اهمیت زیادی دارد.ش
انواع پتری دیش بر اساس جنس
جنس پتری دیش تأثیر مستقیمی بر مقاومت، کاربرد و حتی دقت آزمایش دارد. رایجترین مواد سازنده عبارتاند از:
شیشهای:
معمولاً از شیشه بوروسیلیکات ساخته میشود که مقاومت حرارتی بالایی دارد. این نوع پتری دیش برای استریل شدن در اتوکلاو یا حتی آون آزمایشگاهی در دمای حدود ۱۲۰ تا ۱۶۰ درجه سانتیگراد کاملاً مناسب است.
پلاستیکی:
اگر نگرانی از آلودگی متقاطع وجود داشته باشد، پتری دیش پلاستیکی انتخاب بسیار خوبی است، زیرا اغلب یکبارمصرف است. با این حال، عملکرد آن در دماهای بسیار پایین چندان مطلوب نیست.
پلیاستایرن:
این مدلها سبک، ارزان و یکبارمصرف هستند و بهطور گسترده در محیطهای صنعتی و بالینی برای آزمایشهای روتین میکروبیولوژی استفاده میشوند.
پلیپروپیلن:
پتری دیشهای پلیپروپیلنی وزن کمی دارند اما در برابر اتوکلاو و مواد شیمیایی مقاوماند. همچنین نسبت به مدلهای شیشهای دوام بیشتری نشان میدهند.
سلولز استات:
این نوع زمانی کاربرد دارد که تبادل گاز اهمیت زیادی داشته باشد. نفوذپذیری بالاتر نسبت به اکسیژن و دیاکسیدکربن، شرایط بهتری برای برخی کشتها فراهم میکند.
نیتریل:
برای کاربردهای دمای پایین گزینهای ایدهآل است و معمولاً بازه دمایی حدود منفی ۳۴ تا ۱۳۵ درجه سانتیگراد را تحمل میکند. این ویژگی باعث میشود در شرایط خاص آزمایشگاهی عملکرد قابل اعتمادی داشته باشد.
انواع پتری دیش بر اساس تعداد محفظهها
برخی مدلهای پتری دیش دارای محفظههای جداگانه هستند. این طراحی اجازه میدهد چند محیط کشت مختلف را در یک پلیت آماده کنید.
تعداد این بخشها معمولاً بین ۲ تا ۴ محفظه متغیر است و برای مقایسه همزمان نمونهها یا انجام چند آزمایش در یک ظرف بسیار کاربرد دارد. استفاده از این نوع پتری دیش علاوه بر صرفهجویی در فضا، باعث افزایش سرعت کار در آزمایشگاه نیز میشود.
کاربردهای پتری دیش؛ از کشت سلول تا پروژههای علمی

پتری دیش ابزار بسیار کاربردی در آزمایشگاه است که کاربریهای متنوعی دارد. مهمترین کاربرد آن، کشت سلولها و میکروارگانیسمها در فضای داخلی ظرف است. این روش به دو دلیل اصلی استفاده میشود:
حفاظت از نمونهها در برابر آلودگیهای محیطی
امکان مشاهده رشد موجودات زنده بدون اختلال، چرا که شفاف بودن شیشه یا پلاستیک اجازه میدهد به راحتی فرآیند رشد را زیر نظر گرفت.
استفاده آموزشی و پروژههای علمی
گاهی اوقات پتری دیش در مدارس و دانشگاهها برای پروژههای علمی مورد استفاده قرار میگیرد، مانند مشاهده جوانهزنی بذرها. این کاربرد به دانشآموزان و دانشجویان کمک میکند تا مفاهیم زیستی را عملی و ملموس تجربه کنند.
اندازهگیری و ذخیرهسازی
برخی مدلهای پتری دیش دارای شبکههای چاپشده در قسمت پایینی هستند که برای اندازهگیری تراکم کشتها کاربرد دارند. علاوه بر این، میتوانند برای نگهداری نمونهها به صورت مایع، دانهای یا اشیای کوچک مانند حشرات و بذرها استفاده شوند.
تبخیر و خشککردن نمونهها
پتری دیشها برای تبخیر و خشک کردن نمونهها نیز مناسباند. این ویژگی در آزمایشهایی که نیاز به کاهش حجم مایعات یا آمادهسازی نمونهها برای مراحل بعدی دارند، بسیار کاربردی است.
ساخت پلیت آگار
یکی از رایجترین کاربردهای پتری دیش، ساخت پلیت آگار است. مراحل ساده آن به شرح زیر است:
- مقدار مناسب آگار را با حجم مشخصی آب مقطر مخلوط کنید.
- در صورت استفاده از محیط کشت مایع (مثل نوتریانت براث)، آن را به مخلوط آگار اضافه کرده و هم بزنید.
- ظرف حاوی مخلوط آگار را برای استریل کردن در اتوکلاو قرار دهید.
- پس از خارج کردن از اتوکلاو، اجازه دهید مخلوط تا دمای قابل لمس خنک شود، اما هنوز در حالت مایع باشد. اگر زمان خنککردن طولانی شود، آگار در داخل ظرف سفت میشود.
- مخلوط مایع را در پتری دیشهای استریل و در محیط آزمایشگاهی بدون آلودگی بریزید. عمق آگار باید حدودا بین ۶ تا ۱۳ میلیمتر باشد. پس از ریختن، ظرف را بچرخانید تا آگار به طور یکنواخت توزیع شود و اجازه دهید سفت شود.
- پس از سفت شدن آگار، درپوش را روی ظرف قرار داده و با پارافیلم ببندید تا از خشک شدن و آلودگی جلوگیری شود.
- پلیتها را تا زمان استفاده در یخچال نگهداری کنید.
- این روش ساده و مؤثر، پایه بسیاری از آزمایشهای میکروبیولوژی و زیستشناسی سلولی است و بدون پتری دیش انجام آن دشوار خواهد بود.
نحوه استفاده ایمن از پتری دیش در آزمایشگاه
- قبل از استفاده، استریل کنید: اطمینان حاصل کنید که ظرفها پیش از کار با نمونهها کاملاً استریل شدهاند.
- پس از استفاده، ضدعفونی و استریل کنید:پتری دیشهای استفادهشده را با محلولهای ضدعفونیکننده مناسب در آزمایشگاه تمیز و استریل کنید.
- نگهداری مناسب: ظرفها را به صورت وارونه در یخچال یا هر سیستم نگهداری مناسب قرار دهید تا رطوبت حفظ شود و خطر آلودگی کاهش یابد.
این اقدامات ساده اما مهم، طول عمر و ایمنی استفاده از پتری دیش را تضمین میکند و باعث میشود نتایج آزمایشها دقیقتر و قابل اعتمادتر باشند.
چرا پتری دیش را هنگام انکوباسیون وارونه قرار میدهند؟

قرار دادن پتری دیش به صورت وارونه در طول انکوباسیون یک روش استاندارد در آزمایشگاه است و دلایل علمی مهمی دارد که در ادامه به آنها اشاره خواهیم کرد:
- جلوگیری از اختلاط کلنیها: در طول انکوباسیون، آب موجود در محیط کشت تبخیر میشود. اگر پتری دیش به حالت معمولی (رو به بالا) قرار گیرد، قطرات آب از درپوش روی محیط کشت میریزد و باعث اختلاط کلنیها میشود. این موضوع رشد میکروارگانیسمها را نابرابر کرده و شمارش دقیق میکروبها را دشوار میکند.
- کاهش تبخیر و خشک شدن محیط: با قرار دادن ظرف به صورت وارونه، سرعت تبخیر آب کاهش مییابد و محیط کشت رطوبت خود را حفظ میکند. این شرایط، محیطی ایدهآل برای رشد یکنواخت میکروارگانیسمها ایجاد میکند.
- کاهش آلودگیها: احتمال نشست آلودگیها روی درپوش بیشتر است. وقتی ظرف وارونه قرار گیرد، تماس آلایندهها با نمونه کاهش مییابد و خطر آلودگی محیط کشت کمتر میشود.
- سهولت در جابهجایی و کار با ظرفها: نگهداری پتری دیشها به صورت وارونه، هم در نگهداری و هم در دستکاری آزمایشها کار با ظرفها را آسانتر میکند.
به طور خلاصه، قرار دادن پتری دیش به صورت وارونه باعث رشد یکنواخت، کاهش آلودگی و حفاظت از رطوبت محیط کشت میشود و یک استاندارد مهم در میکروبیولوژی است.
نکات احتیاطی هنگام استفاده از پتری دیش

استفاده ایمن و دقیق از پتری دیش نیازمند رعایت چند نکته ساده اما حیاتی است:
- استریلسازی یا دفع صحیح: قبل و بعد از استفاده از پتری دیش، آن را به طور کامل استریل کرده و به روش صحیح دفع کنید تا از گسترش آلودگی جلوگیری شود.
- استفاده از دستکش: همیشه هنگام کار با پتری دیش از دستکش استفاده کنید تا نمونهها و محیط کشت از آلودگی محافظت شوند.
- انجام آزمایش در محیط استریل: تمامی آزمایشها باید در محیطی استریل و کنترلشده انجام شود تا خطر آلودگی و خطای آزمایش به حداقل برسد.
مزایا و محدودیتهای پتری دیش؛ همه آنچه باید بدانید
پتری دیش ابزار ساده اما بسیار کاربردی است که مزایا و محدودیتهای خاص خود را دارد. شناخت آنها به شما کمک میکند تا استفاده مؤثر و ایمنتری از این ابزار داشته باشید.
مزایای پتری دیش
فضای مناسب برای کشت سلولها: پتری دیش فضایی امن و کنترلشده برای رشد و تکثیر سلولها و میکروارگانیسمها فراهم میکند.
جلوگیری از آلودگی: درپوش و بستهبندی مناسب از ورود آلودگیهای محیطی جلوگیری میکند.
تنوع در اندازه و شکل :وجود انواع مختلف پتری دیش باعث میشود کاربرد آن در آزمایشگاه گستردهتر شود و برای اهداف متفاوت مناسب باشد.
شفافیت ظرف: شفاف بودن شیشه یا پلاستیک اجازه میدهد نمونهها بدون برداشتن درپوش مشاهده شوند، بدون اینکه محیط کشت به خطر بیفتد.
قابلیت استفاده مجدد (در مدل شیشهای): پتری دیشهای شیشهای پس از استریلیزاسیون دوباره قابل استفاده هستند که از نظر اقتصادی مقرونبهصرفه است.
محدودیتهای پتری دیش
نیاز به کاربر ماهر: اگر فرد استفادهکننده تجربه کافی نداشته باشد، احتمال آلودگی همیشه وجود دارد.
محدودیت جنس ظرف: جنس پتری دیش (شیشه یا پلاستیک) ممکن است برای برخی سلولها مناسب نباشد یا روی آزمایشهای حساس تأثیر بگذارد.
عدم شبیهسازی شرایط فیزیولوژیکی واقعی: محیط داخل پتری دیش نمیتواند کاملاً شرایط طبیعی رشد سلولها یا میکروبها را بازسازی کند.
سخن پایانی
پتری دیش یک ابزار ساده اما حیاتی در آزمایشگاههای زیستشناسی و میکروبیولوژی است. این ظرف کمعمق و شفاف امکان کشت و بررسی سلولها و میکروارگانیسمها را به شکلی ایمن و کنترلشده فراهم میکند. در طول مقاله با تاریخچه، اجزا، انواع، کاربردها، مزایا و محدودیتهای آن آشنا شدیم و نکات ایمنی و نحوه صحیح استفاده را بررسی کردیم.
باید توجه داشت که انتخاب این ابزار بسته به نوع آزمایش، محیط کشت و نیاز تحقیقاتی متفاوت است و هر مدل ویژگیهای منحصر به فرد خود را دارد. از پتری دیشهای شیشهای قابل استفاده مجدد گرفته تا مدلهای پلاستیکی یکبارمصرف با شبکه شمارش، تنوع وسیعی وجود دارد که هر کدام مزایا و کاربردهای خاص خود را دارند.






